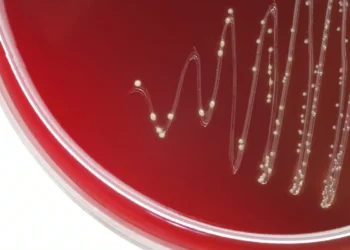
باکتریهای دهانی می توانند عامل حملات قلبی باشند

آزمایش موفق موشک پدافند هوایی ASTER
12 مرداد 1404
۱۰ هواپیمای جنگنده برتر نسل پنجم حال حاضر دنیا
15 تیر 1404 - بهروزشده در 4 مرداد 1404
معرفی بهترین فیلم های سینمایی جهان
2 خرداد 1404 - بهروزشده در 20 خرداد 1404
زیردریایی دستساز کشاورز چینی با موفقیت به اعماق آب رفت
28 تیر 1404 - بهروزشده در 31 تیر 1404
همکاری لایکا و Capture One آغاز شد
26 آذر 1404
ورود فورد به بازار ذخیرهسازی انرژی
26 آذر 1404